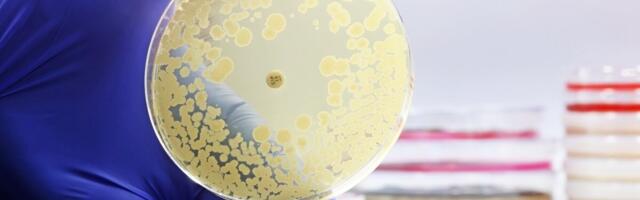
Eesti teadlased: Ukraina rindelt võivad Euroopasse liikuda superbakterid

364 koht 0
Eesti teadlased hoiatavad, et kuna sõjas ei ole kellelgi aega mõelda antibiootikumide vastutustundliku kasutamise peale, võime olla üsna kindlad, et antibiootikumidele resistentsete bakterite levik kasvab plahvatuslikult.
Tähtsamad uudised sinu postkastis!
Saadame välja 10 olulisemat Eesti uudist keskpäeva paiku igapäevases uudiskirjas. Vajuta nuppu ja me saadame sulle vaid kõige tähtsamad uudised ja koroonaviiruse infot ja ei saada spämmi.
Pane LIKE Facebook-is ja ära maga maha päeva kõige tähtsamat uudist!
1930. aastatel ehk Eesti laskmise kuldajal suuri tegusid teinud sportlasest Elmar Kivistikust on ilmunud Tiit Lääne koostatud raamat "Maailma parim laskur Elmar Kivistik." Vaata lähemalt ›
0 uustulnuk
Riigifirma Eesti Energia on välja mõelnud uut tüüpi elektrilepingu, mille puhul inimene saab fikseeritud elektri hinna teada alles peale lepingu sõlmimist. Vaata lähemalt ›
0 uustulnuk
Tiitlikaitsja hiinlane Zhao Xintong kaotas snuukri maailmameistrivõistluste veerandfinaalis Shaun Murphyle 10:13. Vaata lähemalt ›
0 värske
Väsimus ja halb tuju: ettevaatust tähemärkidega, kes võivad sinu energiat kurnata foto : Canva Väsimus, ärritus, meeleolu langus… Mõned kohtumised jätavad meid täiesti tühjaks veel mitmeks tunniks. Olgu tegemist sõbranna, pereliikme, kolleegi või ülemusega — on inimesi, kelle kõrval tunned pärast, nagu kogu energia oleks sinust välja imetud. Astroloogia järgi on olemas mõned tähemärgid, keda võib pidada tõelisteks energiavampiirideks. Nad vajavad palju tähelepanu, kinnitust, kuulamist ja emotsionaalset koh Vaata lähemalt ›
0 värske
Peeter Oja rääkis "Psühhos", et on väga valus, kui terav kriitika tuleb inimeselt, kellest ta lugu peab. Mihkel Raud tõdes, et avaliku elu tegelasel peabki paksem nahk olema ja temagi on otse-eetris intervjueeritavale verbaalselt kallale läinud. Poliitik Kajar Lember tunnistas, et tema elas raske aja üle ise enda üle nalja heites. Vaata lähemalt ›
0 värske
Tervisekassa arengukava perioodil on kavas vaadata, kuidas on võimalik tervishoiusüsteemi tõhustada, kuid praegune teadmine ütleb, et suure tõenäosusega vajab defitsiidis eelarvega tervisekassa lisarahastust, ütles "Esimeses stuudios" tervisekassa juht Siiri Lahe. Vaata lähemalt ›
0 värske
USA president Donald Trump teatas, et tal oli kolmapäeval Venemaa režiimi juhi Vladimir Putiniga väga hea vestlus. Vaata lähemalt ›
0 värske
Jäära naine: iseloom, sobivus armastuses, tugevused ja nõrkusedfoto: Canva Iseseisev ja kirglik Jäära naine ei jää kunagi märkamatuks. See tulemärk, kelle sünniaeg jääb vahemikku 21. märts – 19. aprill, liigub läbi elu julgelt, kiiresti ja kindla sihiga. Ta on sündinud kevade esimese sädemega — energiline, võluv, ettevõtlik ja vaba hingega. Jäära naine teab väga hästi, mida ta tahab, ning enamasti ka seda, kuidas seda saada. Ent selle vallutaja välimuse... Vaata lähemalt ›
0 värske
Kurlingu segapaaride MM Šveitsis Genfis pole Marie Kaldvee ja Harri Lille jaoks sujunud päris loodetult ja nii ollakse alagrupiturniiri viimase vooru eel seisus, kus edasipääs ei sõltu enam ainult enda mängust. Vaata lähemalt ›
0 värske
Eesti tehnoloogiaettevõte Spiral Hydrogen on rohelise vesiniku tootmiseks loonud meetodi, mis lahendab sajandivanuse probleemi ja võib muuta vesinikuenergia senisest oluliselt odavamaks ning kättesaadavamaks. Ettevõte on kaasanud 2,7 miljonit eurot investeeringuid ja rajab oma esimest piloottehast Euroopa ühte suurimasse tööstuskeskusesse, Rotterdami sadamasse. Vaata lähemalt ›
0 värske
Genfis jätkuval kurlingu segapaarismängu MMil said Marie Kaldvee ja Harri Lill kolmapäeval kaks tähtsat võitu: esmalt alistati Prantsusmaa 8:4, seejärel Taani 10:7. Play-off'i pääsemine selgub homses viimases voorus. Vaata lähemalt ›
0 värske
Venemaa president Vladimir Putin pakkus kolmapäeval välja relvarahu Ukrainas toimuvas sõjategevuses 9. maiks, mil Venemaa tähistab Nõukogude Liidu teise maailmasõja aegset võitu Natsi-Saksamaa üle, teatas Kreml. USA president Donald Trump kiitis algatust. Vaata lähemalt ›
0 värske
KLÕPS | Birgit Sarrapi tütar tähistas märgilist sünnipäeva uhke pidžaamapeoga Vaata lähemalt ›
0 värske
Kuigi võimalikud kandidaadid ise ei pruugi selleks veel oma mõtetes täielikult valmis olla, on Eesti Olümpiakomitee presidendiralli alanud, sest aeg surub takka. Vaata lähemalt ›
0 värske
Eelmise aasta lõpus peeti Küprosel kinni telefonipettustes süüdistatav Artur Yermolayev, kes on nüüd läinud prokuratuuriga kokkuleppele ja maksab tuvastatud Eesti ohvritele tagasi 5,4 miljonit eurot. Lisaks saab Eesti riik Yermolayevilt veel 3,1 miljonit eurot, seda kohtukulude katteks, ja jääb veel ülegi. Vaata lähemalt ›
0 värske
Võimsa lõpuspurdi teinud Kaldvee ja Lill said üliolulise võidu ning säilitasid edasipääsulootuse Vaata lähemalt ›
0 värske
Kremli abiline_ Putin tegi Trumpiga peetud telefonikõnes ettepaneku võidupüha relvarahuks Vaata lähemalt ›
0 värske
Eesti kurlingupaar Marie Kaldvee - Harri Lill alistas Genfis toimuvatel maailmameistrivõistlustel Taani 10:7 ja säilitas võimaluse pääseda medalimängudele. Vaata lähemalt ›
0 värske
Nutirakenduse kasutamine koos personaalse tagasiside ja järk-järgulise nõustamisega aitas vähendada rasedate liigset kaalutõusu ning hoida see sagedamini soovituslikes piirides, selgus värskest kliinilisest uuringust. Vaata lähemalt ›
0
Tartu ülikooli silmakliiniku juhataja Kuldar Kaljurand ja meditsiiniajaloo nooremlektor Ken Kalling esitlevad reedel trükisooja raamatut “Maarjajää ja laseriga. Poolteist ja enam sajandit silmaravi Tartus”. Vaata lähemalt ›
0
Soome valitsus püüab sotsiaal- ja tervishoiuvaldkonna kulude kokkuhoiuks tõsta olemasolevaid ja kehtestada uut tüüpi tasusid. Tõusevad näiteks tervisekeskuste ja hambaravi visiiditasud ning lisandub eriuuringutasu. Vaata lähemalt ›
0
Harju maakohtu ja Tallinna ringkonnakohtu otsusega ettevõtluskeelu saanud Tallinnas tegutsenud perearst Konstantin Ivanov jäi eelmisel nädalal (15.04) ilma ka nimistust. Vaata lähemalt ›
0
Harju maakohtu ja Tallinna ringkonnakohtu otsusega ettevõtluskeelu saanud perearst Konstantin Ivanov jäi eelmisel nädalal (15.04, toim) ilma ka nimistust. Vaata lähemalt ›
0
Retseptiravimite kuritarvitamine on Soomes suur probleem: sealse tervise- ja heaoluinstituudi andmetel on ligi 400 000 soomlast neid tarvitanud retsepti omamata või vastupidiselt juhistele. Ravimeid on hangitud ka sotsiaalmeediast või arsti pettes. Vaata lähemalt ›
0
Retseptiravimite kuritarvitamine on Soomes suur probleem: sealse tervise- ja heaoluinstituudi andmetel on ligi 400 000 soomlast neid tarvitanud retsepti omamata või vastupidiselt juhistele. Ravimeid on hangitud ka sotsiaalmeediast või arsti pettes. Vaata lähemalt ›
0
Taani ravimitootja Novo Nordisk suukaudne GLP-1 ravim alandas oluliselt II tüüpi diabeediga laste ja noorukite veresuhkru taset, saavutades hilise staadiumi uuringu peamise eesmärgi. Sellest võib saada esimene lastel heaks kiidetav GLP-1 ravim. Vaata lähemalt ›
0
USAs läbi viidud ulatuslik kohortuuring näitas, et keha kuju ja kõhupiirkonda kogunenud rasva hulk on seotud suurema suremusriskiga. Uuringus kasutatud BRI on suhteliselt uus näitaja, mis arvestab lisaks pikkusele ka vööümbermõõtu ning peegeldab seetõttu paremini vistseraalse rasva hulka. Vaata lähemalt ›
0
Eesti tervishoiusüsteemi jätkusuutlikkus ei sõltu ainult rahastusest, sama tähtis on mõtestada spetsialistide rollid ümber ja siduda haridus tihedamalt tööeluga, kirjutab Tallinna tervishoiu kõrgkooli õppeprorektor Ulvi Kõrgemaa. Vaata lähemalt ›
0
Populaarsemad allikad
|
|
0% |
|
|
0% |
|
|
0% |
|
|
0% |
|
|
0% |
| Vaata allikaid » | |
Pane LIKE Facebook-is ja ära maga maha päeva kõige tähtsamat uudist!
29.04.2026 23:18
Viimane uuendus: 23:14.
Uudiste reiting uuendatud: 23:10.
Mis on Uudis.net?
Uudis.net näitab populaarsemate uudiste edetabelit erinevatest Eesti uudisteportaalidest.
Meie tööpõhimõttetest loe lähemalt KKK rubriigist.
Keele valik
Српски / srpski Eesti keel (Eesti uudised) Русский язык (новости Эстонии) Українська мова (новини Естонії)